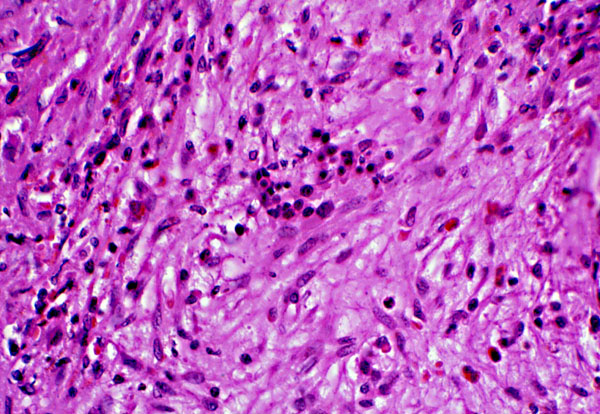

Marked fibrosis, bone marrow biopsy, histology
Click picture to enlarge. Close window to return
This medium power view of a bone marrow shows prominent fibrosis, with lacy pink collagen fibers evident. A few scattered hemopoietic cells are embedded in the fibrotic stroma, with a cluster of erythroid precursors observed in the center of the slide.